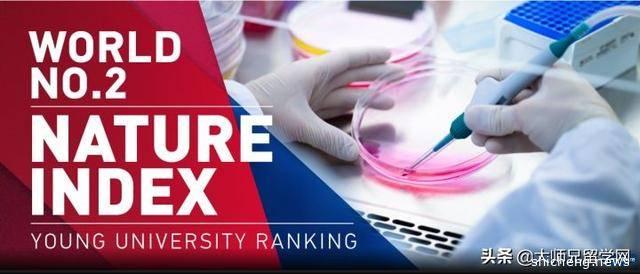

新加坡本科留学丨新加坡南洋理工大学(NTU)本科申请条件
新加坡南洋理工大学是新加坡的一所科研密集型大学,分文、理、工、商四大学院,2020年泰晤士高等教育世界大学排名第48名,2020年QS世界大学排名第43名,2020年US.news世界大学排名,该校本科的申请条件是怎样的呢?废话少说,咱们开始!
本文共包含3部分:院校简介丨本科入学标准丨专业设置及费用详情
【院校简介】

新加坡南洋理工大学为3万3千名本科生和研究生提供全方位的跨学科教育。南大也与伦敦大学帝国学院联办李光前医学院,并在2013年录取第一批学生。新加坡南洋理工大学也设有四所世界级的自主机构。包括拉惹勒南国际关系研究院、新加坡唯一的专业师资培训学府——国立教育学院、集中研究地球科学自然灾害课题的新加坡地球观测与研究所,以及研究重点放在生物膜的新加坡环境生物工程中心。
南大也设有许多顶尖的研究中心,包括南洋环境与水源研究院和南洋理工大学能源研究所。除了着重科研建设,我们还计划借助现有的优势,在可持续发展、新创意媒体、保健医疗体制科技、新丝绸之路和创业创新生态模式五个方面,再攀高峰,致力将南大打造成一所卓越的环球大学。
新加坡南洋理工大学在新加坡设有两个校区。主校区是占地200公顷、坐落在新加坡西南部的南大云南园校区,设有18个学生宿舍,为学生提供丰富多彩的住校生活,让他们有机会接受历练,提升领导才能,加强独立意识。除了主要的云南园校园,南洋理工大学也在位于诺维娜的新加坡医疗区设立校园。
在南大,每10名学生当中就有8名学生到海外的高等学府修读相关科目、参加交流活动或国际竞赛等。同时,学生们也能在企业机构和工业园区实习并进行研究。南大的合作伙伴和国际联盟不断增加,为学生制造更多机会前往顶尖大学和知名企业进修实习。其中包括劳斯莱斯公司、洛克希德·马丁公司和宝马公司等。
【本科入学标准】

1.高考成绩要求
南大本科课程在中国内地招生的对象为已经参加过高考或即将在6月参加高考的学生。
•已参加高考-高考分数达到一本线;
•未参加高考(在籍高三生)-优异的高一和高二成绩;
•安生世界名校英才遴选暨育工程(ACEIS)-如有参加英文、数学、物理考试可直接通过安生报名。
2.英语要求
•托福(TOEFL)–网络考试iBT至少90分或笔试pBT至少600分;
•雅思(IELTS)–总分至少6.0;
•SAT–总分至少1900(2017年三月前考取)或1250(2017年改革后新SAT);
•PTE学术英语考试(PTE Academic)–总分至少55;
•安生(AMESON)英语考试–至少140分。
•ACT考试包含作文测试(ACT with Writing)–总分至少30分。
(以上为大部分课程最低入学要求。非工、理课程、医科、双学位及双主修课程对英语有较高
的要求。)
3.其他要求
所有国际学生在注册成为南洋理工大学学生前须完成12年基础教育。取得我校入学资格的中国学生必须在注册为我校学生前完成高中三年学习并呈上高中毕业证书。
注意:
1.由于名额有限,入场竞争激烈,尤其是对于国际学生。入学点每年不同,在不同的课程之间也有所不同。满足最低要求并不能保证您可以入读NTU的任何课程。
2.录取决定的主要因素是高中学习成绩。
【专业设置及费用详情】

新加坡南洋理工大学本科课程共涉及10个领域,数百专业,具体领域如下:会计与商业、艺术,设计与媒体、传播学、教育学、工程学、人文科学、药学、科学、社会科学、体育科学。
1.学费
所有学士学位课程(除下列七个课程):17,550新币
会计学士学位:20,100新币
商业学士学位 :20,100新币
会计与商业双学士学位 :20,100新币
计算机工程与商业双学士学位 :20,100新币
医学学士学位:74,900新币
文艺复兴时期的工程学士学位:38,300新币
2.生活费(每月)
住宿费(校内宿舍): 255新币(双人间),590新币(单人间)。
餐费:300-400新币。
交通、 书本、个人消费: 320 - 540新币。
每月总计: 875 - 1530新币(约和4349~7604人民币)
评论